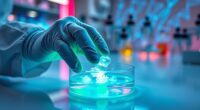
bio art ethical concerns

Living sculptures are innovative art pieces that combine biological elements with artistic design, creating semi-living, evolving works. These artworks often integrate microorganisms, plants, or tissues that grow, breathe, and respond to their environment. Artists use special materials and technologies to care for and monitor the liveliness of these works. If you want to discover how these dynamic creations challenge traditional art and connect us more deeply with nature, keep exploring this fascinating world.
Key Takeaways
- Living sculptures are semi-living artworks that incorporate biological components capable of growth and response.
- Artists like Oron Catts and Ionat Zurr pioneer integrating tissues and organisms into dynamic, evolving sculptures.
- These artworks use biodegradable supports, controlled environments, and biotechnologies to sustain vitality and aesthetics.
- Ethical considerations involve responsible sourcing, maintenance, and ensuring ecological sustainability of living elements.
- Exhibitions feature immersive, interactive experiences that engage viewers through tactile, sensory, and environmental interactions.

HYUGF Moving Sand Art Picture Decor, 3D Deep Sea Sandscape Liquid Motion, Round Glass Frame Display Flowing Sand Relaxing Gift for Kids Adults Home Office Work Desktop Decoration Toy (Black, 7")
【Magnificent Dynamic Sandscape】- The dynamic sand picture can be rotated freely in 360, every time you turn it,…
As an affiliate, we earn on qualifying purchases.
As an affiliate, we earn on qualifying purchases.
The Evolution of Living Art: From Traditional to Semi-Living Works

The evolution of living art reflects a shift from purely organic creations to more integrated, semi-living works that blur the line between nature and technology. This progression emphasizes biological integration, where living elements are carefully combined with artistic structures to create dynamic, evolving pieces. Unlike traditional art forms, semi-living artworks require ongoing care to guarantee their vitality, making art preservation a crucial aspect of their existence. Artists now focus on maintaining the health of living components while enhancing aesthetic appeal, pushing boundaries beyond static displays. This transformation allows you to experience art that interacts with its environment and changes over time, reflecting a deeper connection between humans and living systems. The use of art preservation techniques is essential to ensure the longevity and health of these living components, bridging the gap between artistic innovation and biological care. As a result, living art becomes a proof of innovation and the seamless merging of organic life with creative expression.

Medium-Brown Tattoo Ink 30ml/1oz Bottle Easy Rich Colors Lasting-Long Color Vibrant Vivid Professional Tattoo Supplies for Artists and Beginners Premium Inks Pigment for Permanent Makeup
54 vibrant colors for your choice: Elevate your art with this tattoo ink-where quality, compassion, and creativity come…
As an affiliate, we earn on qualifying purchases.
As an affiliate, we earn on qualifying purchases.
Techniques and Materials Behind Living Sculptures

Creating living sculptures requires a careful selection of techniques and materials that support both artistic vision and biological health. You focus on botanical integration, blending plants seamlessly into the artwork, and biological augmentation to enhance vitality. Key methods include:
- Using biodegradable supports that nourish the living components, guaranteeing longevity.
- Incorporating microclimates and controlled environments to promote healthy growth.
- Applying biotechnological tools to monitor and optimize biological functions.
- Ensuring color accuracy and appropriate lighting conditions to support plant health and visual appeal.
These techniques enable artists to craft dynamic, sustainable works that evolve over time. The materials chosen—such as organic substrates, growth mediums, and bio-compatible structures—are essential for maintaining the sculpture’s vitality. Mastering these methods ensures your semi-living artwork remains vibrant, thriving, and true to your creative vision.

SOFLIY 3D Dynamic Sand Art Liquid Motion, Moving Sand Art Picture Round Glass 3D Deep Sea Sandscape in Motion Display Flowing Sand Frame Relaxing Desktop Home Office Work Decor (Green, 12")
Lead-free high transparency glass as clear crystal as the water drop allows you to fully enjoy the beauty…
As an affiliate, we earn on qualifying purchases.
As an affiliate, we earn on qualifying purchases.
Notable Artists Pioneering Living Artforms

Innovative artists are pushing the boundaries of traditional art by developing living works that breathe, grow, and change over time. Pioneers like Oron Catts and Ionat Zurr combine biological augmentation with artistic vision, creating semi-living sculptures that integrate seamlessly into their environment. Their work often involves cultivating living tissues or organisms, blurring the line between art and biology. These artists focus on environmental integration, designing artworks that respond to external stimuli or adapt naturally. By harnessing cellular growth and biological processes, they challenge conventional notions of permanence and art’s role within ecosystems. Their innovative approaches inspire viewers to rethink the relationship between living systems and creative expression, emphasizing sustainability and interconnectedness in modern art. Understanding biological augmentation is essential for appreciating how these artworks evolve and interact with their surroundings. These trailblazers are reshaping what art can be in the age of biological and environmental hybridity.

Living Matter: The Preservation of Biological Materials in Contemporary Art: An International Conference Held in Mexico City, June 3–5, 2019
As an affiliate, we earn on qualifying purchases.
As an affiliate, we earn on qualifying purchases.
Ethical Considerations and Future Directions

As living artworks become more prevalent, ethical questions surrounding their creation, treatment, and implications demand careful consideration. You must address biological ethics, ensuring that living components are responsibly sourced and maintained without harm. Sustainability challenges also come into play, as these artworks often rely on resources that may strain ecosystems. To navigate these issues, consider these points:
- Prioritize ethical sourcing of biological materials to prevent harm.
- Develop sustainable practices that minimize environmental impact.
- Establish guidelines for the respectful treatment and care of living components.
- Regularly assess headphone compatibility to ensure safe and effective integration with various devices and prevent potential damage.
Experiencing Living Sculptures: Exhibitions and Interactive Installations

Experiencing living sculptures in exhibitions and interactive installations immerses you in a dynamic fusion of art and biology. You become part of a scene where nature integration blurs boundaries, inviting you to observe living forms that respond and evolve. These displays heighten sensory engagement, as you touch, listen, and even smell the artworks, deepening your connection. Interactive elements encourage active participation, making you a collaborator rather than a passive viewer. As you explore, the living components react to your presence, creating a dialogue between viewer and sculpture. This immersive experience transforms traditional art into a lively, multisensory encounter, emphasizing the fragile beauty of living materials and fostering a profound appreciation for the delicate balance of nature. Discover a free tool to transform text capitalization styles
Frequently Asked Questions
How Do Living Sculptures Maintain Their Health Over Time?
To keep living sculptures healthy, you should regularly monitor plant health and adjust nutrient management accordingly. Water them consistently, ensuring they don’t dry out or get overwatered, and provide the right amount of sunlight. Prune dead or unhealthy parts and fertilize as needed to promote growth. By actively caring for your sculpture’s plants, you help maintain their vigor and keep the artwork vibrant over time.
What Are the Environmental Impacts of Creating Semi-Living Artworks?
Creating semi-living artworks impacts the environment by increasing your ecological footprint, but you can reduce this by choosing sustainable materials. Using eco-friendly resources minimizes harm to ecosystems and conserves resources. You’re responsible for evaluating the environmental impact of your materials and processes, making mindful choices that support sustainability. This way, your art can inspire creativity while respecting the planet, ensuring your work remains environmentally conscious and ethically sound.
Are There Legal Regulations Governing Living Sculptures in Public Spaces?
Yes, there are legal frameworks and public space regulations governing living sculptures in public areas. You need to verify local laws, permits, and zoning rules before installing or displaying such artworks. These regulations often address safety, environmental concerns, and public liability. By adhering to public space regulations, you ensure your living sculpture complies with legal standards and avoids potential issues with authorities or the community.
How Do Viewers Typically React to Interactive Living Artworks?
You often find yourself captivated, as viewers usually have a strong emotional response to interactive living artworks. Their engagement can be like sparks flying in a dark room, igniting curiosity and wonder. People tend to react with amazement, delight, or even surprise, enthusiastic to connect with the living element. This emotional response deepens the experience, making the artwork feel alive and personal, transforming the audience into active participants in the creative process.
Can Living Sculptures Be Customized for Specific Themes or Messages?
Yes, living sculptures can be customized for specific themes or messages. You can explore various customization options, such as adjusting the materials, colors, and movement patterns to fit your vision. Thematic adaptations allow you to convey particular ideas or emotions, making your artwork more meaningful and engaging. By tailoring these elements, you create a semi-living sculpture that resonates with your intended message and enhances viewers’ experience.
Conclusion
Living sculptures push the boundaries of art and challenge your perceptions of life and creativity. As these semi-living works evolve, they invite you to rethink what art can be—dynamic, interactive, and ever-changing. Will you embrace these innovative forms and see the beauty in their delicate balance between nature and human ingenuity? By exploring living sculptures, you become part of a ongoing dialogue about the future of artistic expression and its impact on society.